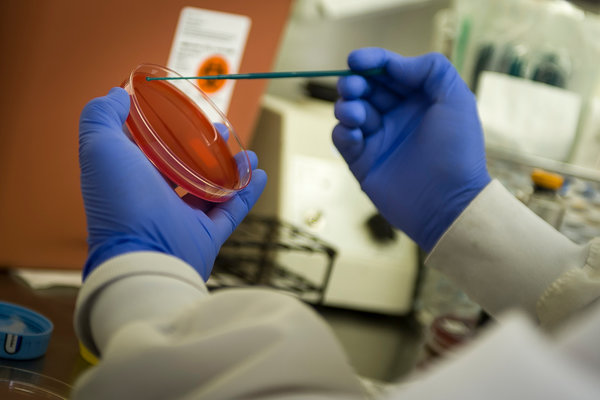

The New York Times today reports, “Hospitals nationwide are hustling to prepare for the first traveler from West Africa who arrives in the emergency room with symptoms of infection with the Ebola virus.
Dr. Thomas R. Frieden, director of the Centers for Disease Control and Prevention, has said such a case is inevitable in the United States, and the agency this month issued the first extensive guidelines for hospitals on how recognize and treat Ebola patients.
The recommendations touch on everything from the safe handling of lab specimens to effective isolation of suspected Ebola patients. But one piece of advice in particular has roused opposition from worried hospital administrators.
The C.D.C. says that health care workers treating Ebola patients need only wear gloves, a fluid-resistant gown, eye protection and a face mask to prevent becoming infected with the virus. That is a far cry from the head-to-toe “moon suits” doctors, nurses and aides have been seeing on television reports about the outbreak.”
Continue reading the main story on The New York Times’ website.